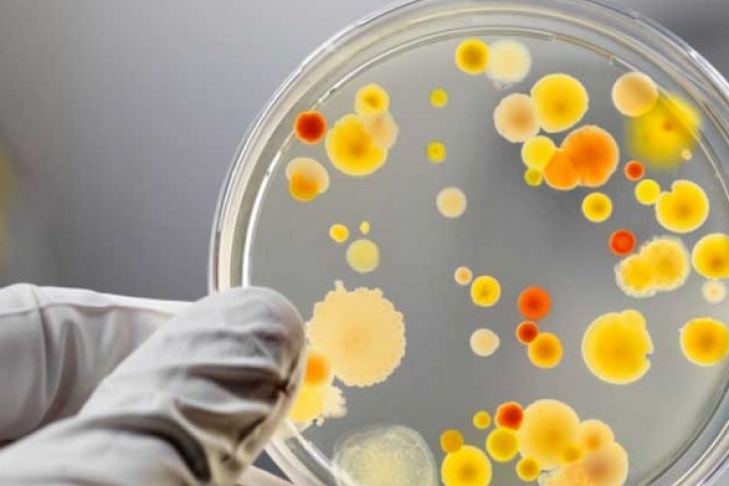

17:59 / 20.03.2018
Здоровье 
Отравление на Львовщине: в восьми жителей диагностировали сальмонеллез
На Львовщине, в Бродовском районе, в восьми жителей, которых на прошлой неделе госпитализировали с пищевым отравлением, диагностировали сальмонеллез. Об этом сообщили в инфекционном отделении Бродовский центральной районной больницы, передает "УНН".
Отмечают, что у госпитализированных на прошлой неделе с пищевым отравлением, диагностировали сальмонеллез.
Пока неизвестно, какие именно продукты были инфицированы сальмонеллой.
Все пациенты находятся на амбулаторном лечении в Бродовский центральной больницы. Среди них трое детей.






 Наука и техника «Успішний тестовий запуск: SpaceX успішно випробувала свою найбільшу ракету (відео)»
Наука и техника «Успішний тестовий запуск: SpaceX успішно випробувала свою найбільшу ракету (відео)»  Происшествия «Справа про "порноофіси": Топпосадовці Нацполіції вийшли під заставу»
Происшествия «Справа про "порноофіси": Топпосадовці Нацполіції вийшли під заставу»  Происшествия «Правоохоронці викрили у Києві розкрадання понад 4 млн грн на закупівлі медичних матеріалів»
Происшествия «Правоохоронці викрили у Києві розкрадання понад 4 млн грн на закупівлі медичних матеріалів»  Политика «Премьер Канады призвал Москву немедленно прекратить атаки и завершить войну против Украины»
Политика «Премьер Канады призвал Москву немедленно прекратить атаки и завершить войну против Украины»  Происшествия «Россия атаковала Павлоград: дроны попали по многоэтажке, бушует пожар»
Происшествия «Россия атаковала Павлоград: дроны попали по многоэтажке, бушует пожар»  Политика «До Києва з візитом прибула лідерка білоруської опозиції Світлана Тихановська»
Политика «До Києва з візитом прибула лідерка білоруської опозиції Світлана Тихановська»